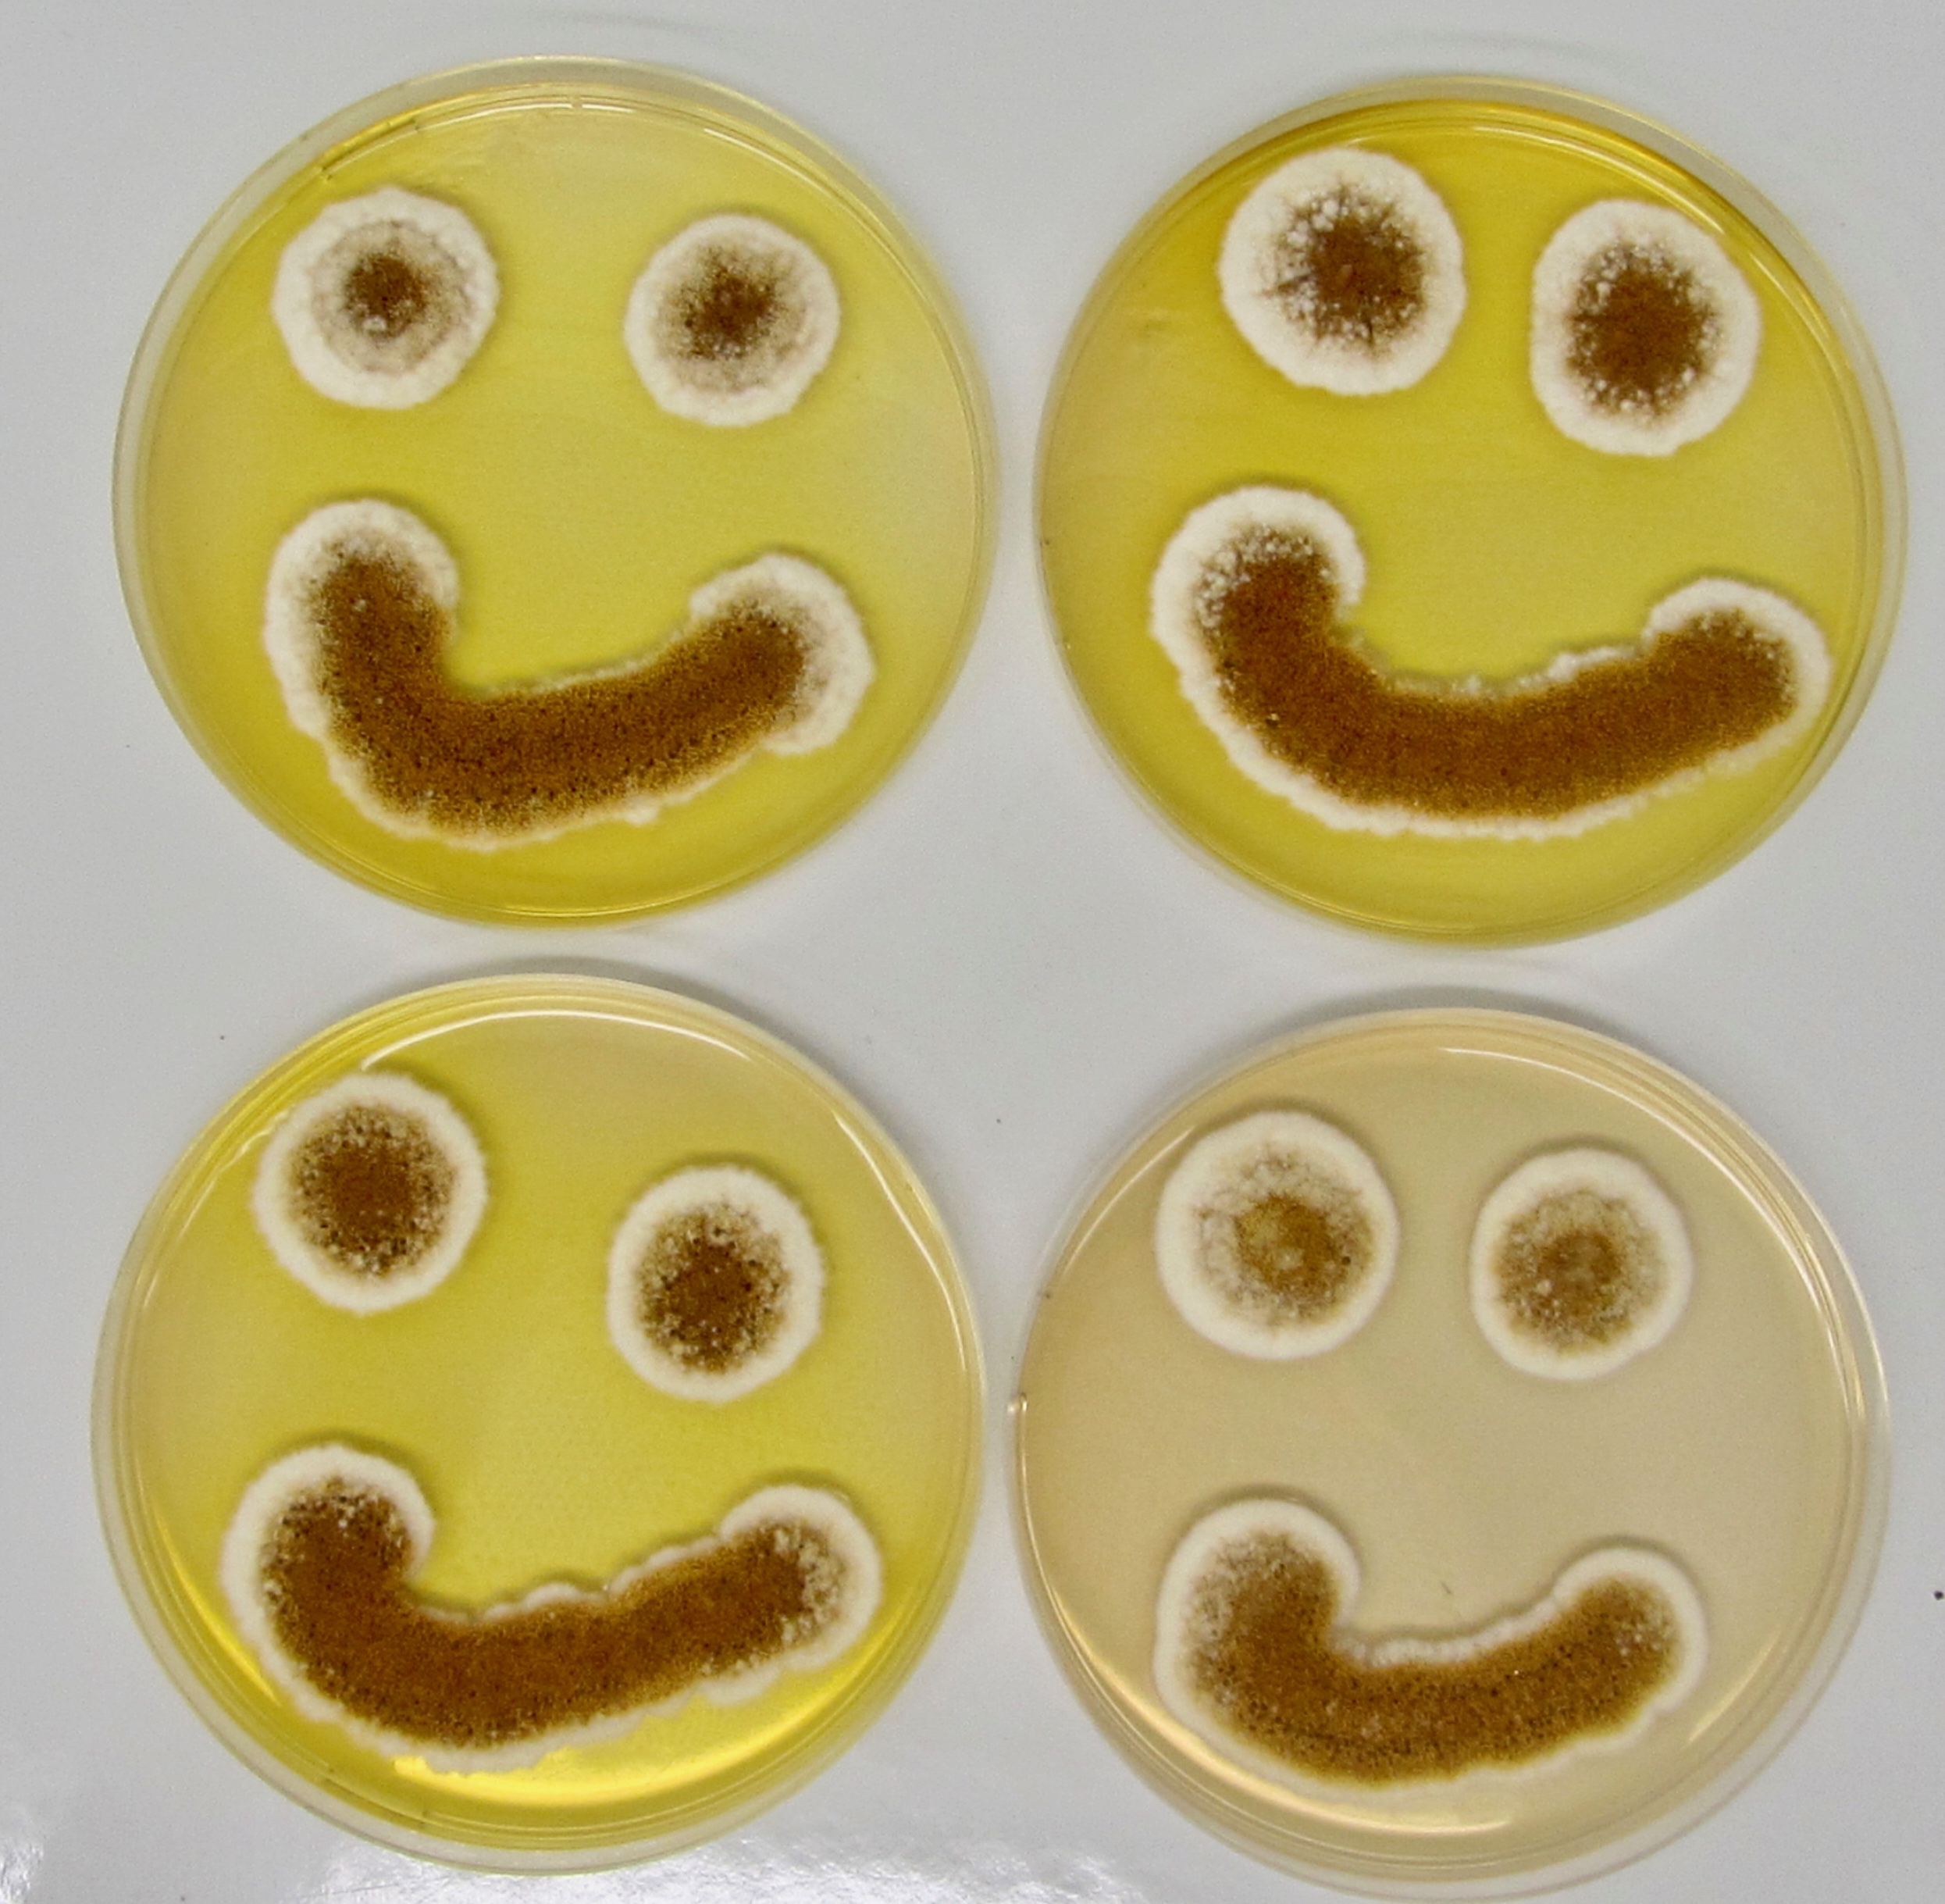
Photo de l'équipe

altération des qualités organoleptiques (aspect, odeur, goût), nutritionnelles et technologiques des aliments (gaspillage alimentaire), productions de composés toxiques (mycotoxicoses), altération de la salubrité des habitations et de la qualité de l’air intérieur (allergies de contact et respiratoires).
Le laboratoire MYCOSCOPIA a pour objectif d’aider toute entreprise, personne confrontée à un problème en lien avec un développement fongique :
– Éleveurs, agriculteurs, vétérinaires, haras, parcs zoologiques, industries agro-alimentaires, fabricants d’aliments… : Aide au diagnostic et conseil en cas de suspicion de mycotoxicose ou d’altération fongique des aliments
– Particuliers, médecins ou conseillers médicaux en environnement intérieur : Évaluation du risque sanitaire associé au développement fongique dans les habitations et les locaux professionnels ou d’élevage
– Monde de la recherche : Identification de nouvelles molécules fongicides, caractérisation de la biodiversité fongique, aide au développement de méthodes rapides de détection